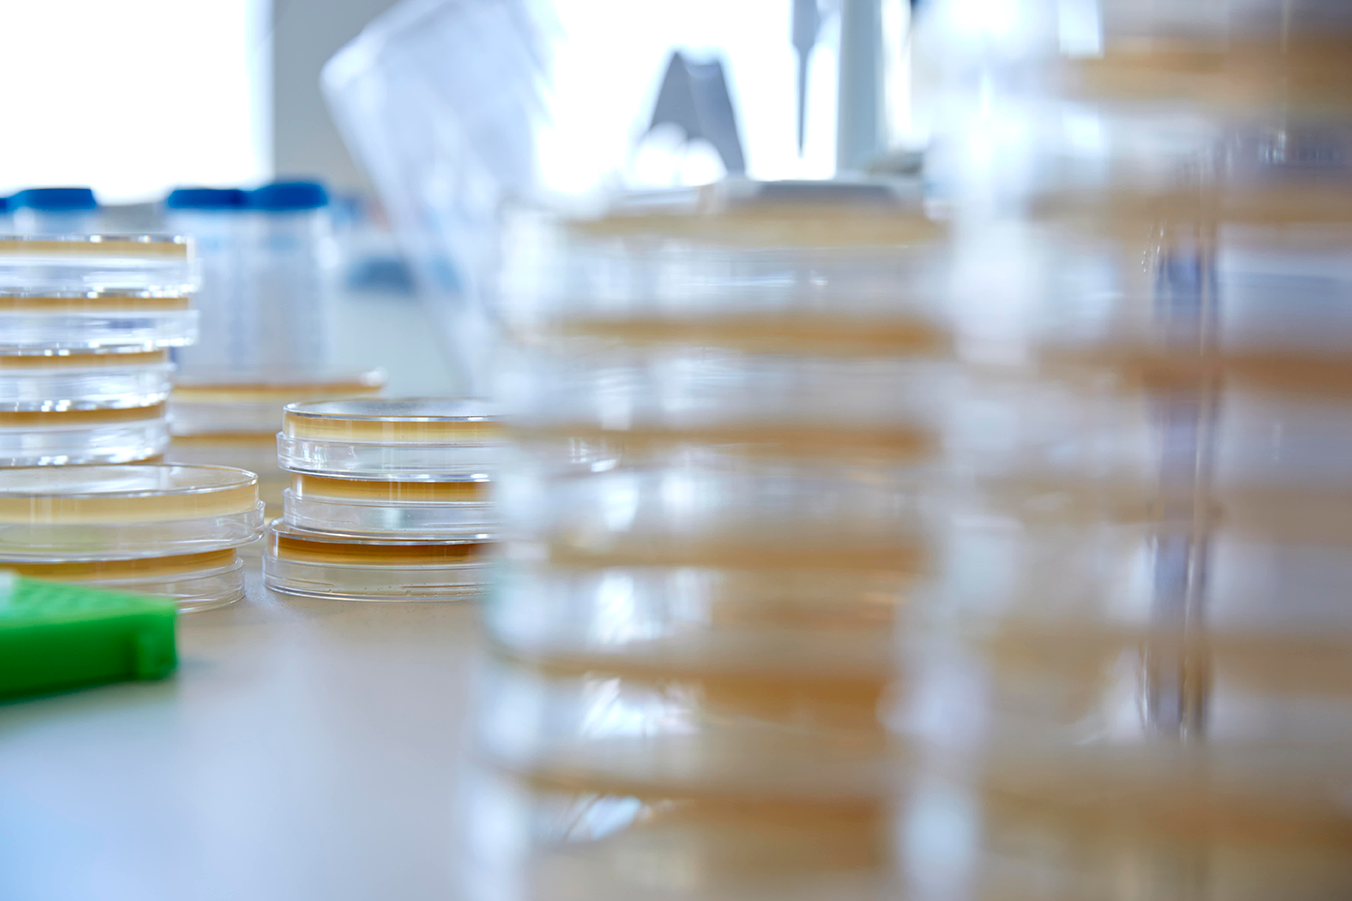
Samples and stacked petri dishes

Collective agreements
If you work in the public sector or at a pharmacy, your employment is typically governed by a collective agreement. In the private sector, however, employment terms are usually set individually—and it's rare to be covered by a collective agreement.

Collective agreement for pharmacy staff
As a pharmacy employee, you’re covered by a collective agreement for pharmacy staff between Pharmadanmark and the Association of Danish Pharmacies.
Collective agreement for employees in the public sector
Are you employed by the state, a region, or a municipality? Then you’re covered by a collective agreement for public sector employees.

Collective agreements for employees in the private sector
Only a few private sector employees in Life Science are covered by a collective agreement. However, Pharmadanmark has negotiated a few collective agreements with private employers.

Collective agreement for Ph.D's
While most Ph.D. positions follow public sector agreements, specific rules and conditions apply depending on your workplace.
Need legal assistance?
Our legal team is here to help.
If you have questions or need support, don’t hesitate to contact our legal advisors.
Call us at +45 3946 3605
Email us at jura@pharmadanmark.dk
